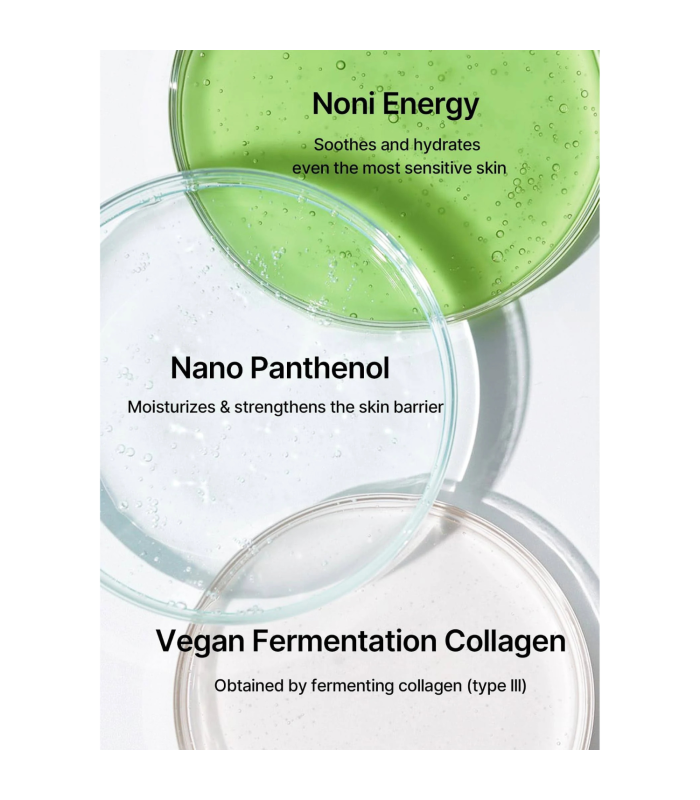
Celimax - The Real Noni Energy Ampoule - Siero viso

Celimax - The Real Noni Energy Ampoule - Siero viso energizzante rivitalizzante e antiossidante
Ampoule nutriente con estratto di noni, squalano e ceramidi per idratare e rafforzare la barriera cutanea. Arricchita con adenosina e sodio ialuronato, aiuta a ridurre le rughe e migliorare l’elasticità, mentre l’olio di rosmarino lenisce e dona vitalità alla pelle.
Celimax - The Real Noni Energy Ampoule è un’ampoule nutriente a base di estratto di frutto di noni, ricco di minerali, vitamine, proteine ed enzimi che nutrono e leniscono la pelle. La combinazione di squalano e ceramidi fornisce un’idratazione profonda e aiuta a rafforzare la barriera idrolipidica. L’adenosina e il sodio ialuronato contribuiscono a ridurre le rughe, migliorare l’elasticità e ammorbidire la pelle. L’olio di rosmarino, con proprietà antinfiammatorie e stimolanti della circolazione, completa la formula donando nutrimento e vitalità. Gli effetti principali includono idratazione, nutrimento, rinforzo della barriera cutanea, ammorbidimento, miglioramento dell’elasticità, levigatezza e azione lenitiva.
Tipo di pelle: Tutti i tipi di pelle, particolarmente indicata per pelle secca, irritata, sensibile e matura.
Modo d’uso: Applicare su pelle detersa e tonificata. Massaggiare il contenuto di una pipetta su tutto il viso fino a completo assorbimento. Utilizzare mattina e sera.
Ingredienti: Morinda Citrifolia Fruit Extract (71.77%), Butylene Glycol, Propanediol, Glycerin, 1,2-Hexanediol, Diethoxyethyl Succinate, Aqua, Sodium Polyacryloyldimethyl Taurate, Chlorphenesin, C12-13 Pareth-9, Sodium Hyaluronate, Melia Azadirachta Leaf Extract, Glyceryl Acrylate/Acrylic Acid Copolymer, Allantoin, Disodium EDTA, Adenosine, Rosmarinus Officinalis (Rosemary) Leaf Oil, Melia Azadirachta Flower Extract, Caprylic/Capric Triglyceride, Theobroma Cacao (Cocoa) Extract, Olea Europaea (Olive) Fruit Oil, Hydrogenated Lecithin, Butyrospermum Parkii (Shea) Butter, Squalane, Dextrin, Phytosphingosine, Cholesterol, Morinda Citrifolia Seed Oil, Ceramide NP.
Avvertenze: Le informazioni riportate sul nostro sito, comprese immagini, descrizioni e ingredienti, sono fornite a scopo informativo e possono essere soggette a modifiche da parte del produttore. Raccomandiamo di leggere attentamente le etichette, le istruzioni e le avvertenze sulla confezione originale prima dell’uso. In caso di dubbi o condizioni particolari, consultate il vostro medico. MewiSkin non è responsabile per eventuali reazioni allergiche o sensibilizzazioni personali agli ingredienti indicati dal produttore, che non costituiscono difetti del prodotto.
Contenuto: 30 ml
Scheda tecnica
- Tipo di pelle
- Matura
Secca e disidratata
Sensibile e reattiva
- Azione
- Anti rossori
Anti-age
Lenitiva
Nutriente
Rafforzamento barriera cutanea
Uniformante
- Ingredienti
- Acido ialuronico
Ceramidi
Celimax è un marchio coreano specializzato nella cura della pelle sensibile e problematica, con un approccio scientifico e trasparente. Ogni prodotto è formulato con ingredienti sicuri, testati e selezionati per offrire risultati visibili senza compromettere l’equilibrio naturale della pelle. Celimax si distingue per le sue soluzioni mirate, che aiutano a lenire irritazioni, ridurre le imperfezioni e migliorare la texture cutanea, rispondendo alle esigenze quotidiane di chi cerca una skincare efficace e delicata.

Lascia una recensione